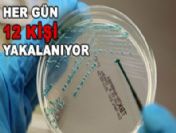

Ölü sayısı 16'e yükseldi
ALMANYA'DA yüzlerce insana bulaşan, ardından İsveç, Hollanda, İngiltere, Fransa, Danimarka ve Avusturya'da da görülen EHEC bakterisi can almaya devam ediyor.
HER GÜN 12 KİŞİ YAKALANIYOR
ÜNIVERSİTELERDE yapılan araştırmalarda Hamburg’da İspanya’dan geldiği tespit edilen 4 salatalıkta ölümcül bakteriye rastlandığı bildirilirken, her gün ortalama 12 insanın bakteriye yakalandığına dikkat çekildi. Öte yandan bakteri Alman çiftçilere büyük darbe vururken İspanya Almanya’ya dava açmaya hazırlanıyor.
